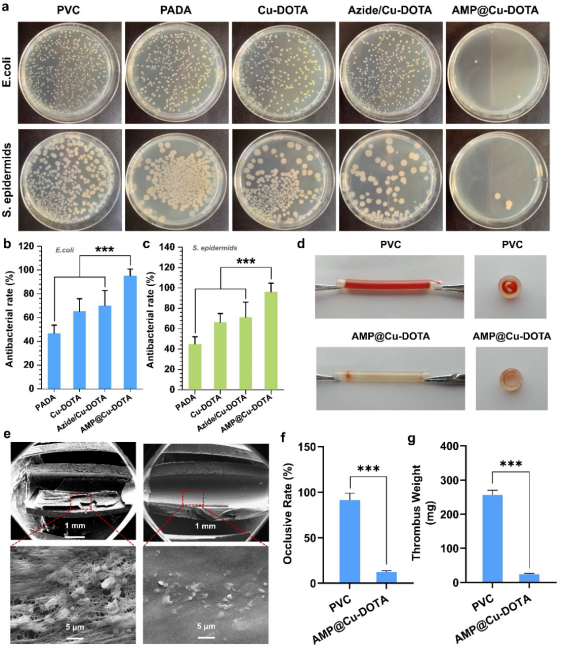

近日,k1体育材料先进技术教育部重点实验室熊开琴工程师、杨志禄研究员及成都市第三人民医院心内科周名纲副主任医师,以公司为第一通讯单位在生物材料领域排名第二的国际期刊Bioactive Materials (IF: 8.724)上发表题为“Nitric oxide-generating compound and bio-clickable peptide mimic for synergistically tailoring surface anti-thrombogenic and anti-microbial dual-functions”的研究论文。
临床上,聚氯乙烯材质的导管在药物输送和体外循环中得到了广泛的运用。然而在长期运用中,其导致的细菌感染与凝血等症状,对患者造成了诸多负担。然而,目前的治疗手段,如使用抗生素与抗凝药物,会导致滋生耐药菌,诱导出血等并发症。因此,对导管进行内表面功能化设计,博得了许多科研人员的青睐。但是,目前常用的功能设计,更多的依然局限于药物包载,或是被动抗黏附等功能,并没有有效解决细菌滋生以及长程的功能实现。相比较聚氯乙烯材料,正常人体内血管内膜微环境中存在着丰富的抗菌多肽,可以有效清除微生物,进而防止细菌黏附形成生物膜和感染;同时,内膜中的内皮细胞会分泌多种信号分子,保持正常的血液流动。因此,人体正常血管具有一定的抗凝血与抗菌的功能,这也为设计导管的功能表面提供了思路。
近日,k1体育十年品牌熊开琴工程师与杨志禄研究员联合成都市第三人民医院心内科周名纲副主任医师,从血管内膜及其微环境仿生设计出发,通过点击化学的方法,构建了一个具有双功能仿生的涂层,用于医用导管内表面的改性,以期解决医用导管在临床运用中导致的凝血与细菌感染等问题 (图1)。在这项设计中,为了充分提供功能分子的接枝位点,预先在导管表面制备富氨基涂层(PADA),之后,将催化NO生成的Cu2+螯合DOTA和内膜微环境中重要的抗菌分子——抗菌多肽(ABP)通过酰胺缩合与点击化学接枝两种方式分别固定在PPAm涂层上。具体地说,首先富含大量氨基的聚烯丙胺(PAa)分子以席夫碱反应和迈克尔加成方式接枝在聚多巴胺涂层表面,从而制备富氨基涂层(PADA)。利用大环多胺(DOTA)对CuII高度螯合作用,制备出CuII-DOTA 配合物,然后通过酰胺缩合反应将CuII-DOTA配合物和Azide(15-叠氮基-4,7,10,13-四氧十五烷酸,其水解后含有羧基和叠氮基团的分子)接枝到在富氨基涂层上,最后通过点击化学反应接枝抗菌多肽。相比较酰胺缩合反应固定,点击化学策略通过“钥匙-锁”的专一结合方式进行分子间的键合,实现了高选择性、近乎完美的可靠性和高收率的特点,并且有效避免了功能分子在接枝时发生失活和设计失败。

图1. 血管内膜微环境仿生双功能涂层的分子结构及其应用于聚氯乙烯导管的表面改性。
为了可以形象介绍血管内膜微环境仿生双功能涂层表面功能化策略的设计,作者概念性展示了构建方法(图1)。同时,作者对该涂层在抗菌抗凝血中的优势进行表征证明的过程中,验证了其具有稳定的NO释放速率,出色的生物相容性、抗菌性能和抗凝血性能。此外,半体内循环研究进一步显示,该涂层改性后表面较临床常用的PVC导管展示了其优秀的临床应用潜力(图2)。这项研究最直接的意义是为临床常用的PVC导管表面进行多功能仿生设计提供了新的设计思路和方向;从应用的价值来看,该项工作不仅分别实现了两个分子的各自功能,而且对于抗炎多肽使用了点击化学的接枝方法,保证了抗炎多肽的功能区域完整。此外,以往双分子进行接枝中,由于存在竞争位点,而位点不足时,接枝比例会无法精确控制;而该设计则通过将DOTA与Azide比例进行调整,间接实现了接枝量可控。本研究的积极成果不仅为多个功能分子表面修饰提供了新的解决方案,而且也为体外循环导管表面仿生设计提供了新的思路,巨大的潜在临床潜力。
图2. 血管内膜微环境仿生双功能涂层的导管实现了优异的抗菌抗凝血性能和临床运用前景。
相关研究成果以“Nitric oxide-generating compound and bio-clickable peptide mimic for synergistically tailoring surface anti-thrombogenic and anti-microbial dual-functions”为题发表在国际著名期刊《Bioactive Materials》(https://doi.org/10.1016/j.bioactmat.2020.11.011)上,公司2018级硕士研究生于涵为该论文第一作者,公司熊开琴工程师,杨志禄研究员和成都市第三人民医院心内科周名纲副主任医师同为该论文的通讯作者;k1体育十年品牌材料先进技术教育部重点实验室/k1体育为论文的第一通讯单位。该研究工作的发表得到了国家重点研发计划及国家自然科学基金等项目的资助。
论文链接:
https://doi.org/10.1016/j.bioactmat.2020.11.011
于涵硕士研究生简介:
k1体育十年品牌,k1体育,2018级在读硕士研究生。主要研究方向为血液接触的植入、介入器械表面多功能化设计与研究。
熊开琴工程师简介:
k1体育十年品牌,k1体育,材料先进技术教育部重点实验室,工程师。主要研究方向为心血管生物材料表面改性和生物相容性研究,聚焦改性血管支架(材料)植入正常或模型动物体内后的相互作用和病理机制;以第一/通讯作者在Bioactive Materials(2篇,IF: 8.724),Langmuir,RSC Advances等国际期刊共发表SCI论文4篇。
杨志禄研究员简介:
k1体育十年品牌,研究员,博士生导师,四川省级人才称号获得者,k1体育十年品牌“扬华学者”。目前,担任KeAi旗下国际期刊Smart Materials in Medicine主编、Bioactive Materials编委及客座编辑、Engineered Regeneration编委。主要研究方向聚焦冠脉血管动脉粥样硬化斑块的病理发生机制、以及针对性用于冠脉/外周血管疾病治疗的纳米靶向药物、药物球囊及具有病灶治愈和血管组织修复功能的血管支架研究;以第一/通讯作者在PNAS,Advanced Science,Research,Biomaterials及Chemistry of Materials等国际知名期刊共发表SCI论文45篇。国际/国内会议大会报告、邀请报告10余次。获得授权发明专利16项(包括美国发明专利1项),其中发展的具有自主知识产权的“具有病灶治愈和血管组织修复功能的可降解支架涂层”技术已成功实现转让(转让费:1500万)。
课题组主页:https://faculty.swjtu.edu.cn/yangzhilu/zh_CN/index.htm
周名纲副主任医师简介:
k1体育十年品牌附属医院、成都市第三人民医院心内科,副主任医师,任四川省心血管专委会委员、医促会心血管专委会委员、成都市冠脉介入学组成员、中国胸痛中心认证核查专家。擅长心血管危重症救治、心肌梗死及高危复杂冠心病的介入治疗和全程管理,熟练掌握和开展多种复杂先进的冠脉介入技术,CTO介入成功率90%以上,业务能力得到业界的广泛认可。积极推广普及冠心病介入技术,帮扶多家三级医院开展冠脉介入诊疗工作。承担及参与省市级课题4项,参编心血管专著1部,发表核心期刊论著10余篇。